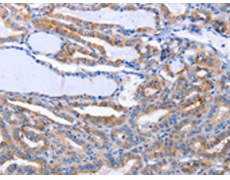
一抗

|
Background: |
The protein encoded by this gene is a pleiotropic cytokine with roles in several different systems. It is involved in the induction of hematopoietic differentiation in normal and myeloid leukemia cells, induction of neuronal cell differentiation, regulator of mesenchymal to epithelial conversion during kidney development, and may also have a role in immune tolerance at the maternal-fetal interface. Alternatively spliced transcript variants encoding multiple isoforms have been observed for this gene. |
|
Applications: |
ELISA, IHC |
|
Name of antibody: |
LIF |
|
Immunogen: |
Synthetic peptide of human LIF |
|
Full name: |
leukemia inhibitory factor |
|
Synonyms: |
CDF, DIA, HILDA, MLPLI |
|
SwissProt: |
P15018 |
|
ELISA Recommended dilution: |
1000-10000 |
|
IHC positive control: |
Human thyroid cancer and Human stomach cancer |
|
IHC Recommend dilution: |
25-100 |

 購(gòu)物車
購(gòu)物車 幫助
幫助
 021-54845833/15800441009
021-54845833/15800441009